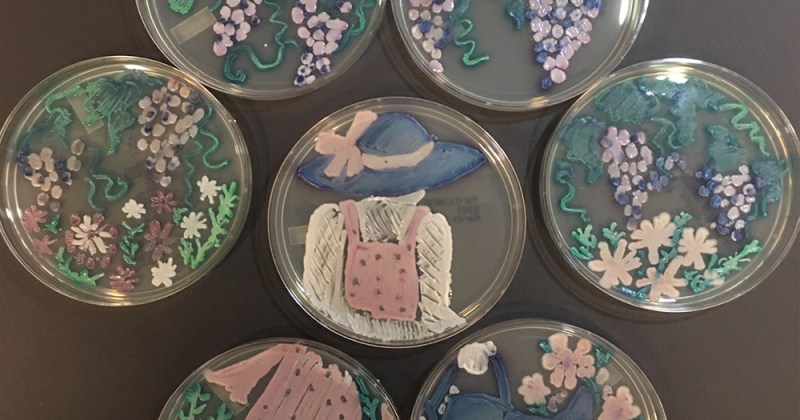

This is a guest post from Dr. Geoff Hunt, Public Outreach Program Officer at the American Society for Microbiology. You can find him on Twitter at @TheGeoffHunt.
Are you a science lover who also enjoys art? Are you a creator at heart? If so, combine your passions by participating in the American Society for Microbiology’s Agar Art Contest!
Agar art is the practice of using microbes to “paint” designs onto agar dishes. Bioartists have used a staggering number of natural and transformed bacteria, fungi and even viruses grown on different media to create works of art. To recognize and share the wonder of this work, ASM has been running the Agar Art Contest since 2015. In that time, we’ve seen thousands of amazing submissions that explore the beauty and artistry of microbes and microbiology, highlighting a wide range of themes and subjects: landscapes, portraits, scientific processes, famous artwork.
Because of this dynamic content, the contest has a wide reach. In 2021, we received 300 entries from 327 submitters in 31 different countries. All submissions are shared online, and our followers vote on their favorites to determine the contest winners.
This online campaign, and the Agar Art contest overall, is part of our effort to connect the broader public with microbiology. Earlier this year, we partnered with Edvotek to host an in-person Agar Art workshop as part of ASM Microbe 2022, our annual society meeting. Dozens of future scientists (and their parents) stopped by to create their own works of bioart. You can read about the event, and see some of the results, here.
Numerous instructors, including middle and high school teachers, as well as undergraduate and graduate faculty, have used Agar Art as a teaching tool to demonstrate microbiological concepts and techniques. In fact, students are typically one of the main groups of submitters to the Agar Art Contest.
This is where you come in. We want you to bring agar art to your labs and classrooms. We want you to encourage your colleagues and your students to submit to the contest. We want you to help spread the word to your non-scientist networks so that they can experience the wonder of science and art.
If you’re looking for supplies to help produce your own agar art, you’ve come to the right place. As in previous years, we’ve partnered with Edvotek to present their do-it-yourself Agar Art kit, which includes reagents and instructional curricula that have been used by teachers and scientists alike. ASM also helps sponsor agar art workshops, hosted by our external partners at locations including community laboratories and academic institutions. You can find a list of upcoming workshops (or apply to host your own) on our website. (Edvotek is giving away one agar art kit so you can try it with your students! Enter here before 09/22/2022.)
As for the contest itself, the year’s version comes with a theme: “My Favorite Microbiologist”. Representation matters, so we want to see the faces and images of the people who do the science. In particular, we are interested in submissions that depict individuals from communities, groups and populations who have traditionally been underrepresented, underserved or outright ignored in the sciences. We hope that by spotlighting these individuals (and their stories), we can contribute in some small way to the societal push towards increasing inclusivity, diversity, equity and access.
Winners are eligible to win up to $100 in prizes (note that only entries submitted to this theme will be eligible to win contest prizes. Of course, you are still welcome to submit entries that do not match the theme, but these entries will not be considered as part of the judging process.) Submissions will be accepted until FRIDAY OCTOBER 28.
I hope you consider submitting, and I’d be happy to answer any questions you may have. Good luck!